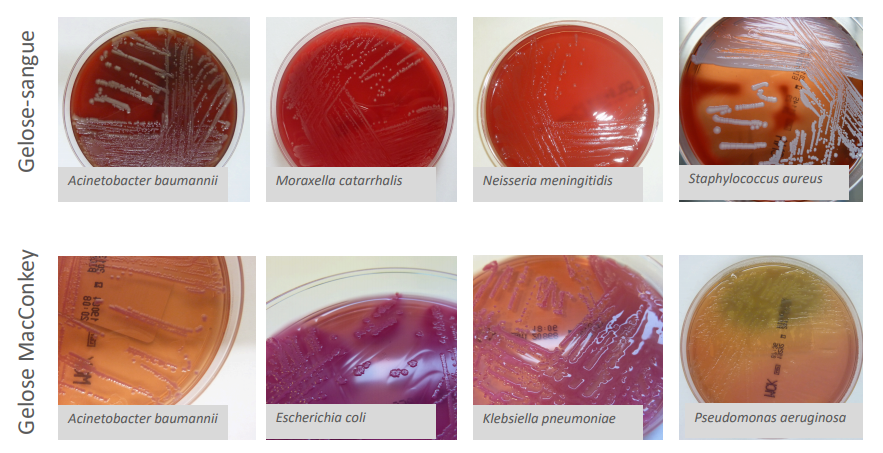

Marcha diagnóstica
- Fase pré analítica: amostra adequada e meio de transporte (se necessário);
- Fase analítica: processamento laboratorial e validação de resultados;
- Fase pós analítica: valorização clínica

Fase Pré-analitica - Avaliação da amostra
- Local;
- Quantidade;
- Timing;
- Recipiente;
- Transporte;
- Preservação;

Métodos de deteção
Pesquisa de:
a) Microorganismo: microscopia e exame cultural:
b) Ag/Ac: serologia;
c) Ácidos nucleicos: diagnóstico molecular;

Exame cultural:
- Observação macroscópica;
- Exame microscópico direto: a fresco e corado;
- Exame cultural;
- Identificação e TSA
Exame directo é a observação microscopica, que pode ser:
- Microscopia ótica:
- De campo claro;
- De campo escuro;
- De contraste de fase;
- Microscopia de fluorescência;
- Microscopia eletrónica;
O exame directo pode ser: Exame a fresco ou exame corado.
Exame a fresco pode ser feito como:
Permite observar (Amplicação de 400x)
- Células;
- Fungos;
- Parasitas;
- Mobilidade bacteriana;
Exame direto (sem manipulação), amostras liquidas
Pode adicionar-se um corante a amostra liquida:
- KOH;
- Azul de lactofenol;
- Iodo;
- Tinta da China;

O exame directo pode ser: Exame a fresco ou exame corado.
Exame corado pode ser feito com:
- Gram (por excelência);
- Ziehl Neelsen (mycobacterium tuberculosis)
As amostras aqui não são liquidas,são fixadas
O exame corado permite a observação com maior amplicação que o exame a fresco (não corado) 1000x.
Só conseguimos caracterizar os MO em grandes ampliações e por isso corados. No exame a fresco permite vê-los ma não caracteriza-los, a não ser que sejam MO grandes como na figura em anexo.

Exame corado pelo Gram tem quantos corantes?
Tem 2 corantes:
- 1º corante: violeta de cristal + Solução iodada: (agarra corante);
- Etanol: descoloração, que vai entrar nalgumas bacterias de parede frágil e remover o corante.
- 2º corante: safranina; As que perderam o primeiro corante vão corar pelo segundo corante.
Gram positivos ficam roxos;
Gram negativos ficam cor de rosa;
MÉTODO:
- I. Realização do esfregaço;
- II. Fixação por calor ou químico;
- III. Corar;
Permite observar:
- Células;
- Fungos;
- Parasitas;
- Morfologia bacteriana;

Exame cultural
- Meios de cultura: sólido vs. líquido:
- Não seletivos (ex: gelose sangue);
- Seletivos (ex: CNA);
- Seletivos e identificadores (ex: MacConkey;)
- Especiais (ex: BCYE;)
(meio em tubo para crescer organismos de crescimento lento, ou bacterias altamente patologicas)
(Meio liquido para quando há urgencia nos resultados, como num caso de sepsis, já que as bactérias crescem mais rápido em meios liquidos)

Identificação bacteriana

- Técnicas manuais;
- Técnicas automatizadas (18-24h):
- Bioquímica;
- Proteómica => + discriminação, demora 5 min;
- Genómica;

TSA
Teste de Sensibilidade aos Antibióticos;
Demora 24h (cultura) + 24h (TSA);
- Técnicas manuais: de difusão ou microdiluição;
- Técnicas automatizadas: de microdiluição ou deteção de genes de resistências;

Cultura celular: prós e contras
Vantagens:
- TSA;
- Estudos epidemiológicos;
- Deteta simultaneamente vários organismos;
- Barato;
Desvantagens:
- Necessita microorganismo viável;
- Demorado;
- Negativo se houve antibioterapia prévia;
- Algumas bactérias não crescem em meios de cultura;
Serologia
(Diagnóstico de fase de coalescência e não de fase aguda).

- Classicamente, deteção de Acs no soro;
- Também se podem detetar Ags no soro (ex: Legionella);
- Desvantagem: não há TSA;
Genómica - Testes TAAN (Testes de amplificação de a´cidos nucleicos)
- Diagnóstico molecular;
- Rápido;
- Pode ser qualitativo ou quantitativo;
- Único ou para múltiplos microorganismos;
- Caro;
- Não precisa de microorganismo vivo;
- Pesquisa de ácidos nucleicos:
- Pesquesa de agente específico: pesquisa de gene da toxina A e B de C. difficile;
- Pesquisa de conjunto de organismos (abordagem sindromática): pesquisa dos agentes causadores de sépsis, infeções respiratórias, infeções GI, infeções do SNC, DSTs;
- Pesquisa de gene de resistência: deteção da resistência à isoniazida e rifampicina no MBT;

Regras de segurança biológica
- Uso de bata obrigatório;
- Higiene das mãos;
- Unhas de gel prejudicam higiene;
- Cabelos compridos apanhados;
- Não ingerir alimentos;
- Não colocar objetos pessoais em cima da bancada de trabalho;
Qual a técnica usada para realizar o exame cultural?
Técnica da sementeira por quadrantes
Gelose simples
- Contém mistura de peptonas particularmente adaptada à cultura de microorganismos mais frequentes em amostras humanas;
- Pode tornar-se enriquecida pela adição de sangue, permitindo o crescimento de bactérias mais exigentes;
- Pode tornar-se seletiva pela adição de misturas antibióticas;
Gelose sangue
- Isolamento de bactérias mais exigentes: gelose simples enriquecida com sangue de carneiro ou cavalo;
- Permite leitura da hemólise;
Gelose chocolate
Isolamento de Haemophilus e Neisseria;
Gelose sangue aquecida para provocar hemólise dos eritrócitos, que assim libertam fatores intracelular essenciais para o crescimento do género Haemophilus: fator V (NAD). A placa fica de cor acastanhada => daí o nome
Gelose chocolate-Haemophilus
- Isolamento seletivo de Haemophilus; Com base nutritiva enriquecida com fator X e fator V produzidos pela hemoglobina e pelo PolyViteX.
- Seletividade é obtida pela associaçção de bacitracina e vancomicina e anfotericina B, para inibir os restantes microorganismos que poderiam crescer
Gelose MacConkey
- Isolamento seletivo e diferenciação de Enterobacteriaceae;
- Contém lactose, permite evidenciar a fermentação lática pela viragem para vermelho neutro (indicador de pH);
- Microorganismos que fermentam latose ficam rosas ou vermelhos;
- Os que não fermentam ficam incolores ou ligeiramente bege;
- Seletividade é proporcionada por sais biliares e cristal de violeta que impedem o crescimento das bactérias Gram positivas;

Gelose SS
- Isolamento seletivo e diferenciação de Salmonella e Shigellla;
- Meio que evidencia colónias fermentadores de lactose e que reduzem tiosulfato por produção de H2S;
- Se fermentar lactose fica cor de rosa, se não fermentar fica incolor;
- Os microorganismos que produzem H2S originam colónias com centro negro; Inibição de crescimento de Gram positivas devido à presença de sais biliares e corantes;
Gelose CLED
- Isolamento de microorganismos presentes na urina;
- Cistina, Lactose, Eletrólito Deficiente;
- Permite diferenciar lactofermentadores dos que não são: os que fermentam a lactose ficam com colónias amarelas ou amarelo esverdeado, e os que não fermentam lactose originam colónias verdes, azuis ou incolores;
- Impede swarming do Proteus: baixa concentração de eletrólitos
Gelose Yersinia (CIN)
- Isolamento seletivo de Yersinia;
- Meio com manitol e vermelho neutro (indicador de pH), permite diferenciação de bactérias do genéro Yersinia;
- Presença de colato, desoxicolato, cristal violeta, Irgasan e antibióticos inibe crescimento de Gram positivas e da maioria das Gram negativas;
- CIN = cefsulodina, irgasan, novobiocina










